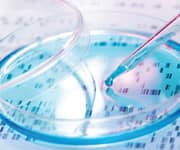
Programming Our Cellular Genes like Computers

Life Extension Magazine®

When I incorporated the Life Extension Foundation®, I envisioned a time when human longevity would not be constrained to a finite number of years.
I was confident technology would emerge to enable science to gain control over pathological aging. When this historic turning point occurs, healthy life spans will extend beyond what anyone imagines today.
Over the past two years, our early predictions have transformed into technical probability.
I am pleased that Life Extension® helped contribute to an emerging gene editing technique that you will learn about in this article.
Even more exciting are human age-reversal studies being designed right now that will be announced in upcoming issues of this publication.
“Editing” our Human Genome In Vivo
As we age, genes that maintain cellular health and vitality are down-regulated. At the same time, genes that promote disease and senescence become over-expressed.
Once physicians are able to precisely program or “edit” DNA genes, then youthful health may be systemically restored.
The name of this new technology is CRISPR. It offers a new way to rapidly transform senescent cells to regain youthful function and structure.
CRISPR is a DNA cutting system originally developed in nature by bacteria as a way to destroy the DNA of viruses that frequently attack them. A natural version of CRISPR has been adapted by scientists to enable the reprogramming of cellular DNA to rid cells of unfavorable genetic changes.
Once perfected, old cells may be rejuvenated and never age again.
Programming Our Cellular Genes like Computers
CRISPR is empowering scientists to do very controlled gene editing, which means adding, disrupting or changing the sequence of specific genes.
This has led to exciting new methods of transiently or permanently modifying gene action, either to increase or decrease the activities of targeted genes in a controllable way, potentially anywhere in the body and anywhere in one’s complete set of genes and DNA (our genome).
Since key features of aging are powerfully controlled by how genes are activated or inactivated (expressed or suppressed) in the body, these are critically important developments.
Introducing the Harvard Pioneer of CRISPR
Dr. George Church is a pioneer in the area of genome engineering and the development of gene editing tools based on the CRISPR/Cas9 system (referred to as CRISPR here).
Dr. Church has already been able to reverse aging in human cells using CRISPR technology, and expects the first clinical trials of this technology to begin within as little as one year.
In response to these breakthroughs, Life Extension Magazine® sent Dr. Gregory M. Fahy to Harvard University to interview Dr. Church. We needed to clarify the opportunities for reversing human aging to save the lives of most of those reading this article now.
The next page contains an introductory article by Greg Fahy, PhD. It then continues with highlights of an exclusive interview with Dr. Church about how CRISPR may soon reverse human aging processes. Readers should appreciate that this novel technology is being developed for the purpose of rapid integration into the human clinical setting.
Is the End of Aging Near at Hand?
By Gregory M. Fahy, PhD

As a student of the aging process, I have been attending scientific meetings devoted to aging since the early 1980s, and I have seen and heard a lot of very exciting things. But when I attended George Church’s talk at a conference sponsored by Aubrey de Grey’s SENS Foundation near the end of 2014, I realized that I had just heard the most exciting talk of my life.
Why? For three very simple reasons.
First, as Dr. Church’s talk highlighted, aging seems to be controlled to a large extent by the action of a rather small subset of your genes, and especially by master genes that control large numbers of other genes. Your genes, of course, are areas of your DNA that determine your eye color, your hair color, your sex, your height, and other characteristics of your body. But what is becoming more and more clear is that genes also determine how you age—and maybe even whether you age, at least in many respects—as well.
Second, Dr. Church described how science has now advanced to the point where the activity of your genes—whether the genes are “turned on” (expressed) or “turned off” (repressed, or down-regulated)—can increasingly be controlled, and not just in a test tube, but in whole bodies, and even in the brain.
And third, Dr. Church fully intends to deploy this technology clinically, i.e., in aging people!
Dr. Church’s focus is on CRISPR technology, which is a relatively new and particularly powerful method for adjusting gene activity in many different ways, and even for “editing”, or changing genes, which can be used to correct deleterious mutations, or to create deliberate mutations that can have good effects (such as in knocking out the effects of pro-aging genes).
So the implication is very clear: If aging is controlled by master genes, and if the activity of such genes can now be intentionally controlled, then we are beginning to approach the control of aging on a very fundamental level. And the same technology can be applied to the correction of many diseases as well, whether age-related or not.
It would do no good to have the power to control aging if there were no will to utilize that power and move aging control to the clinic. Fortunately, that is not the case with Dr. Church. He wants to make the control of aging a practical reality—and soon. And Dr. Church, as a highly distinguished professor of genetics and major figure at Harvard Medical School and in science worldwide, is in an excellent position to make his wishes come true.
In an interview with the Washington Post at the beginning of December 2015,1 Dr. Church said that his lab is already reversing aging in mice, and that human applications may only be a few years away. Dr. Church stated:
“One of our biggest economic disasters right now is our aging population. If all those gray hairs could go back to work and feel healthy and young, then we’ve averted one of the greatest economic disasters in history.”1
He said he sees:
“A scenario [in which] everyone takes gene therapy—not just curing rare diseases like cystic fibrosis, but diseases that everyone has, like aging.”1
Dr. Church also described his personal passion in reversing human aging when he stated:
“I ’m willing to become younger. I try to reinvent myself every few years anyway.”1
So, what is “CRISPR,” this new technology that may change the world, and our lives, as we know them?
The word “CRISPR” is an acronym. What it stands for is unintelligible to anyone but a geneticist, but that doesn’t matter. What matters is that it’s a technology originally developed to fight microorganisms by cutting their DNA, but that it has now been modified by scientists to enable them to make very well controlled changes in very specific places in DNA. Once physicians are able to regulate or “edit” the DNA medically, then youthful health may be restored to an individual.
How serious is the promise of CRISPR? Consider the following:
- A newer version of CRISPR was recently packed into a re-engineered virus delivery system and successfully used to correct the gene defect that causes Duchenne muscular dystrophy in a mouse model. This is done by direct injection into a leg muscle or infusion into the bloodstream. The results are improvements in the muscles throughout the body and even in the heart;2
- On January 7, 2016, Dr. Church’s company, Editas Medicine, filed papers to launch a $100 million IPO, and the company is already being backed by Google Ventures and the Bill and Melinda Gates Foundation.3
In short, in my estimation, the CRISPR revolution is a game changer, with staggering implications. If it all works out, nothing is going to remain the same. The prospects are as transformative as—if not more transformative than—such revolutions as the advent of the electric light, telephones, automobiles, airplanes, personal computers, the internet, and cell phones. Only this time, it’s not just about how you live, but whether you live, and how long you will live: your health, your longevity, and the effect that health and longevity will have on your enjoyment of life.
Will it really work? We will see. Opinions vary. Surely, there will be many tricks to learn and many twists and turns along the road ahead. And heavyweight scientist Craig Venter even says it will take 100 years to get it right. But George Church’s lab is reversing aging in the laboratory today, and so far, it’s looking very good, moving with incredible speed, and based on a very solid foundation of scientific observations about aging. My money is squarely on Church and others pursuing similar paths.
The Life Extension Foundation is dedicated to improving healthy longevity and has assisted Dr. Church by providing him data from a human super-centenarian research project Life Extension has funded.
What Dr. Church is working on pushes the ultimate limits of improving healthy longevity, with potentially open-ended possibilities. The following page begins with highlights from an extensive interview I had with Dr. Church in his office at Harvard Medical School.
I hope you appreciate the substantive nature of what we think is likely to be a coming revolution that may touch your life in important ways.
Gene Editing with CRISPR Technology
Interview of Dr. George Church conducted by Gregory M. Fahy, PhD

Fahy: If aging is driven by changes in gene expression, then the ability to control gene expression using CRISPR technology could have profound implications for the future of human aging. Why do you think aging may be at least partly driven by changes in gene expression?
Church: We know that there are cells that deteriorate with age in the human body and that we have the ability to turn those back into young cells again. This means we can effectively reset the clock to zero and keep those cells proliferating as long as we want. For example, we can take old skin cells, which have a limited lifetime, and turn them into stem cells (stem cells are cells that can turn into other kinds of cells) and then back into skin cells. This roundtrip results in the skin cells being like baby skin cells.4 It’s as if my 60-year-old cells become 1-year-old cells. There are a variety of markers that are associated with aging, and those all get reset to the younger age.
Fahy: So CRISPR has allowed you to reverse aging in human cells. CRISPR is an exciting technology. The CRISPR molecular machine—consisting of a protein and some associated RNA—can now be made in the lab or in our own cells and can change genes and gene expression. It’s extremely powerful. Please tell us more about it.
Church: CRISPR is the latest method for performing genome editing (editing of your whole set of genes). Its advantage is in part that a specific CRISPR tool can be created far more easily than other gene editing tools, and CRISPR is about 5 times more precise than other tools. The combination of the ease of construction, improved efficiency, and great flexibility makes it the most powerful gene-editing tool to date.
Fahy: Right now, with CRISPR, it is possible to modify, delete, insert, activate, and tone down or completely inactivate any gene, with considerable fine-tuning, either temporarily or permanently. The implications for aging may be profound. How does CRISPR edit genes?
Church: The way CRISPR works classically is by cutting DNA so many times in a specific place that eventually an error in DNA repair is made at the location of the cut, and you end up with a random change in the DNA—a mutation—at that location. For that kind of change, the longer CRISPR is around, the more likely you are to accomplish a random mutation, and that can be good if you want to inactivate a troublesome gene, since usually a random mutation will in fact inactivate the gene.
But newer versions of CRISPR are more interesting because they allow you to not just make cuts in DNA, they allow you to splice a particular new piece of DNA, which can do new things, into your genome at a precise location.
To Read Entire Dr. Church Interview
CRISPR technology is rapidly emerging and Greg Fahy, PhD, conducted an extensive interview with Dr. Church at Harvard that is too long to include in this issue of Life Extension Magazine®.
For those who want to read this entire interview, it is available free of charge by logging on to:
Please be advised that some of the content of the expanded interview will include technical details that most readers will find difficult to comprehend.
What’s important to know is that the ability to reverse human aging processes using CRISPR/Cas9 technology may occur in as little as five years according to an article about Dr. Church’s research appearing in a recent edition of the Washington Post (Dec 2, 2015) titled:
“A Harvard professor says he can cure aging, but is that a good idea?”
Our only question is why would anyone ask whether a “cure for aging” is good idea? We at Life Extension® view it as the most momentous initiative in medical history. Life Extension is simultaneously pursuing additional research initiatives aimed at reversing human aging via other mechanisms of action.
Fahy: To reverse human aging, CRISPR technology will ultimately have to be applied in the whole body, and not just to cells in a test tube. How feasible is it to apply CRISPR technology in the intact body?
Church: Gene therapy can be based on either ex vivo manipulations, in which cells are removed from the body, genetically modified, and then put back into the body, or on in vivo (within the body) methods, in which, for example, a modified virus might be used to carry a gene package into many different cells in the body. Each of these methods has pros and cons.
There are viral and non-viral delivery systems that could be used to deliver CRISPR constructs and that will leave the blood vessels and go into the tissues. The delivery system could contain the CRISPR plus guide RNA plus the donor DNA, or it could just comprise the CRISPR, guide RNA, and protein activator, and so on. But whether it’s a viral delivery or a non-viral delivery method, the total mass of gene editing devices that has to be delivered will have to be considerable. But there is no rush, you can deliver them slowly.
Fortunately, there are ways to manufacture biologicals that are very economical. Things like wood and even food and fuel are all roughly in the dollar-per-kilogram range. If we could similarly make a kilogram of a viral delivery system and load it up with CRISPR, then it could become inexpensive enough to apply to the whole body.
Fahy: Is it going to be affordable for a human to reverse his or her aging process using this kind of approach?
Church: If you look at the current price, it looks very unaffordable. There are about 2,000 gene therapies that are in clinical trials, but the only gene therapy that’s approved for human use costs over $1 million per dose. You only need one dose, but at that cost it’s obviously unattainable for most people. It’s the most expensive drug in history, as far as I know.
Fahy: What is that drug?
Church: It’s called Glybera®. It treats a rare genetic form of pancreatitis. But sequencing the human genome used to cost $3 billion per person, and now has come down to just $1,000 per person, so I think getting from over $1 million down to the thousands shouldn’t be that hard.
Fahy: Another cost saver for aging intervention would arise if we could roll back aging significantly just by modifying five to ten genes. That might get the overall cost down to something attractive.
Church: Right. The combination of having to hit, say, a trillion cells in the whole body and 10,000 genes would be daunting. But if you can do a subset of cells and a subset of genes, then it becomes more feasible to make it affordable.
Fahy: Is the fact that the FDA does not recognize aging as a disease a problem?
Church: The FDA is willing to regulate many symptoms of aging, such as osteoporosis, muscle decay, heart disease, mental agility, and so forth. It tends to be harder to prove a preventative than it is to prove a drug that cures an immediately and hugely harmful disease. And actually, since the FDA doesn’t want you making unjustified health claims of any kind, they would have to take responsibility for regulating any health-related condition that one might want to make claims about. It doesn’t have to actually be a disease.
Fahy: It has been proposed that the FDA should just evaluate safety and not efficacy. How do you feel about that?
Church: I really like that. The Internet will probably weed out the non-efficacious. The nutritional supplement market is a perfect example of safety being all that is needed for approval. You can get a nutritional supplement on the market just based on safety, but you can’t get a prescription drug on the market just based on safety. It really should be the same rule.
Fahy: Perhaps if that were altered in favor of the standards for supplements, we’d have many more drugs and would all be a lot better off.
Church: Yes. Focusing on safety is probably the right model.
Life Extension Foundation Funding of CRISPR Research
By Ben Best
The May 2013 issue of this publication reported on how the Life Extension Foundation was funding the collection and analysis of genes of supercentenarians (people living to age 110 or older) to discover protective genes that allow them to live so long.
This funding was provided to a group called Androcyte LLC that initially consisted of CEO James Clement and his assistant, Parijata Mackey. They traveled the world to collect tissue samples from approximately 60 supercentenarians and their family members. Harvard Medical School geneticist Dr. George Church was collaborating with Androcyte to analyze the genes.
Since then, Dr. Church has achieved additional fame as being a co-inventor and pioneer in the new CRISPR gene-editing technology. Also since then, the Life Extension Foundation continued to fund Androcyte to open a laboratory in California dedicated to applying CRISPR to deliver longevity genes, initially to mice. Androcyte CEO James Clement continues to work with Dr. Church in doing this research.
Androcyte currently has a colony of 300 mice, and growing. Sixty of these mice were received from the National Institutes of Aging and are between 26 and 36 months of age—the equivalent of very old humans.
Androcyte has targeted about 25 promising longevity genes, which are being tested in the mice via CRISPR/Cas9 gene therapy. Particular attention is being paid to the elderly mice to see if they can be restored to youth and good health.
To keep costs low, Androcyte purchased a one-acre property with an existing 1,500 square foot building which is an hour’s drive from Los Angeles. As it outgrew its initial vivarium (housing for mice), it added two office trailers to the property to provide additional vivarium and laboratory space.
In addition to Dr. Church and other expert consultants, Androcyte CEO James Clement has acquired the assistance of two new interns: Ellie Dubrovina and David Falzarao, who were referred by Aubrey de Grey’s SENS Foundation. Ellie assists with the scientific work, whereas David assists with the care of the mice.
Androcyte has also received two elderly Arabian mares 28 and 30 years old (age-equivalent to 80-year-old humans) from a sanctuary. If genes delivered by CRISPR to the mice are able to restore youth and health, CRISPR delivery of those genes will be tested on the horses to show that large animals can also benefit. Success with the horses could pave the way for using CRISPR to bring better health and greater longevity to humans.
If you have any questions on the scientific content of this article, please call a Life Extension® Wellness Specialist at 1-866-864-3027.
References
- Available at: https://www.washingtonpost.com/news/achenblog/wp/2015/12/02/professor-george-church-says-he-can-reverse-the-aging-process. Accessed April 12, 2016.
- Available at: http://today.duke.edu/2015/12/crisprmousedmd.Accessed April 12, 2016.
- Available at: http://www.dddmag.com/news/2016/01/google-backed-gene-editing-startup-files-100m-ipo. Accessed April 12, 2016.
- Studer L, Vera E, Cornacchia D. Programming and reprogramming cellular age in the era of induced pluripotency. Cell Stem Cell. 2015;16(6): 591-600.

